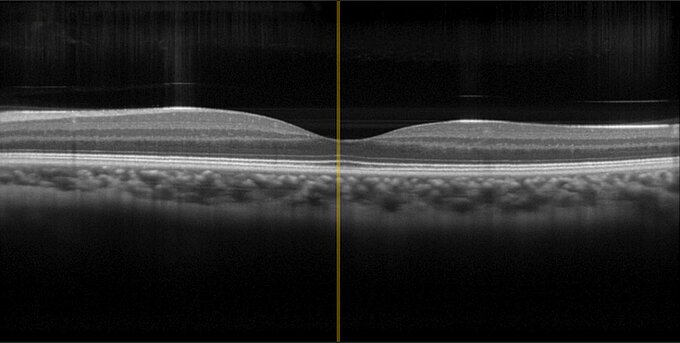
Physik Instrumente OCT Test Image

用于显微镜物镜的PIFOC聚焦扫描仪,高精度,快速步进和稳定,100µm,电容传感器,Sub-D接头
P-725.xCDE2 用于显微镜物镜的PIFOC聚焦扫描仪
动态扫描,行程为100µm、400µm或800µm
- 行程为100µm、400µm或800µm
- 与机动化驱动器相比,具有明显更快的响应和更长的使用寿命
- 亚纳米级分辨率的物镜精密定位
- 电容传感器进行直接测量:高线性度
- 通光孔径高达29mm










应用领域
- 超分辨率显微镜
- 光学圆盘显微镜
- 共聚焦显微镜
- 双光子显微镜
- 3D成像
- 筛选
- 干涉测量
- 测量技术
- 自动聚焦系统
- 生物技术
- 半导体检测
PICMA®压电陶瓷促动器带来超长使用寿命
PICMA®压电陶瓷促动器为全瓷绝缘。 这可以防潮,避免漏电流增大造成故障。 PICMA®促动器的使用寿命是传统的聚合物绝缘促动器的十倍。 它们被证明可实现无故障运行1000亿个循环。
带电容式传感器,实现亚纳米分辨率
电容传感器以亚纳米分辨率进行测量,且无接触。 它们可确保优异的运动线性度、长期稳定性和千赫兹范围的带宽。
零间隙的柔性铰链导向机构带来超高导向精度
柔性铰链导向无需维护、无摩擦、无磨损,无需润滑。 其刚性可实现高负载能力,且它们对冲击和振动不敏感。 其可在较宽的温度范围内工作。
规格
Datasheet P-725.xCDE2
规格
| 运动 | P-725.1CDE2 | P-725.4CDE2 | P-725.8CDE2 | 公差 |
|---|---|---|---|---|
| 主动轴 | Z | Z | Z | |
| Z向上的行程 | 100 µm | 400 µm | 800 µm | +20 % / -0 % |
| Z向上的开环行程 | 120 µm | 420 µm | 840 µm | ±20 % |
| Z向上的线性误差 | < 0.03 % | < 0.03 % | < 0.03 % | |
| 绕X的角度误差 | ± 10 µrad | ± 10 µrad | ± 50 µrad | |
| 绕Y的角度误差 | ± 10 µrad | ± 45 µrad | ± 50 µrad | |
| 定位 | P-725.1CDE2 | P-725.4CDE2 | P-725.8CDE2 | 公差 |
| Z向上的最小位移 | 1 nm | 4 nm | 5 nm | |
| 点重复精度,10%步长,1 σ | 10 nm | 10 nm | 50 nm | |
| 集成传感器 | 电容式,直接位置测量 | 电容式,直接位置测量 | 电容式,直接位置测量 | |
| 传感器噪声,1 σ | 0.2 nm | 0.2 nm | 0.8 nm | |
| Z向上的位置噪声 | 0.1 nm | 0.1 nm | 0.4 nm | max. |
| Z向上10%步长的稳定时间 | 14 ms | 22 ms | 39 ms | ±10 % |
| 驱动性能 | P-725.1CDE2 | P-725.4CDE2 | P-725.8CDE2 | 公差 |
| 驱动类型 | PICMA | PICMA | PICMA | |
| Z向上的电容 | 3.2 µF | 6.4 µF | 12.8 µF | ±20 % |
| 机械性能 | P-725.1CDE2 | P-725.4CDE2 | P-725.8CDE2 | 公差 |
| Z向上的刚性 | 0.5 N/µm | 0.25 N/µm | 0.07 N/µm | ±20 % |
| Z向上的谐振频率,空载 | 680 Hz | 400 Hz | 230 Hz | ±20 % |
| 在150g负载下Z向上的谐振频率 | 290 Hz | 175 Hz | 110 Hz | ±20 % |
| Z向上的允许推力 | 100 N | 100 N | 100 N | max. |
| Z向上的允许拉力 | 20 N | 20 N | 20 N | max. |
| 导轨 | 带杠杆放大的柔性铰链导轨 | 带杠杆放大的柔性铰链导轨 | 带杠杆放大的柔性铰链导轨 | |
| 总质量 | 280 g | 280 g | 350 g | ±5 % |
| 材料 | 不锈钢,铝 | 不锈钢,铝 | 不锈钢,铝 | |
| 物镜直径 | 39 mm | 39 mm | 39 mm | max. |
| 其他 | P-725.1CDE2 | P-725.4CDE2 | P-725.8CDE2 | 公差 |
| 工作温度范围 | 10至70 °C | 10至70 °C | 10至70 °C | |
| 连接器 | D-sub 7W2(公头) | D-sub 7W2(公头) | D-sub 7W2(公头) | |
| 电缆长度 | 1.5 m | 1.5 m | 1.5 m | +50 mm / -0 mm |
| 推荐控制器/驱动器 | E-709.1C1L - 性价比之选,适用于大多数应用场景; E-754.1CD - 高性能选择,实现高精度 | E-709.1C1L - 性价比之选,适用于大多数应用场景; E-754.1CD - 高性能选择,实现高精度 | E-709.1C1L - 性价比之选,适用于大多数应用场景; E-754.1CD - 高性能选择,实现高精度 |
线性误差:只有使用推荐的数字控制器才能达到规定值。
稳定时间:1%误差范围,负载为150g时
位置噪声:
物镜不在发货范围内。
PI技术数据是在22±3°C环境温度下定义的。除非有特别说明,所有数值均基于无负载的情况。某些性能参数是相互关联的。“typ.”标识 是指属性的统计平均值,并非承诺每个交付产品均达到该数值。在产品交付前的最后检验中,我们只检测选定的属性,而不是全部属性。请注意,产品的某些特性可能会随着使用时间的增长而逐渐下降。
下载
数据表
Datasheet P-725.xCDE2
文件
安装说明P725UM0002
用于P-725.xCDE2 PIFOC聚焦扫描仪的螺纹转接头
3D模型
P-725.xCDE2 3D模型
报价/订购
就所需数量、价格和供货周期请求免费报价或描述您所需的改型。
用于显微镜物镜的PIFOC聚焦扫描仪,高精度,快速步进和稳定,400µm,电容传感器,Sub-D接头
用于显微镜物镜的PIFOC聚焦扫描仪,高精度,快速步进和稳定,800µm,电容传感器,Sub-D接头
如何获取报价
询问工程师
通过电子邮件或电话从当地PI销售工程师处快速获取解答。
应用

基因组测序
蓝色、棕色还是绿色的眼睛?哪种发色?哪些疾病会影响我们的健康?我是谁的孩子?所有这些信息以及更多信息均存储在或至少根植于我们的基因中。在犯罪小说以及现实生活中,如果要寻找“是谁干的”这一问题的答案,则需要进行基因分析以寻求线索。. “基因指纹”已成为常供参考和明确无误的证据。最后但同样重要的是,基因组分析是获得许多与健康相关问题的突破性发现的关键。

IsoView光片显微镜
光片显微镜是一项具有吸引力的技术,在生命科学和生物技术中有着巨大的应用潜力。IsoView是这项技术的出色诠释,尤其适用于在数小时内对大型标本进行快速细胞动力学成像。标本定位和物镜平移在IsoView的设计中起着重要作用。

GATTAscope (TIRFM)
线性平台在TIRF显微镜中调整激光束。样本的精密定位可通过组合两个XY位移平台来实现。

共聚焦显微镜
共聚焦显微镜通过聚焦面移动来检测样本表面的结构,例如用于皮肤病检测。
光学相干断层扫描
压电陶瓷促动器和驱动器(例如PILine® OEM电机)可确保光学相干断层扫描(OCT)所需的高精度和位置稳定性。

高速显微镜
在原子力显微镜中,试片在AFM扫描器上通过压电陶瓷扫描台实现定位,因此该扫描台具有非常关键的作用。























